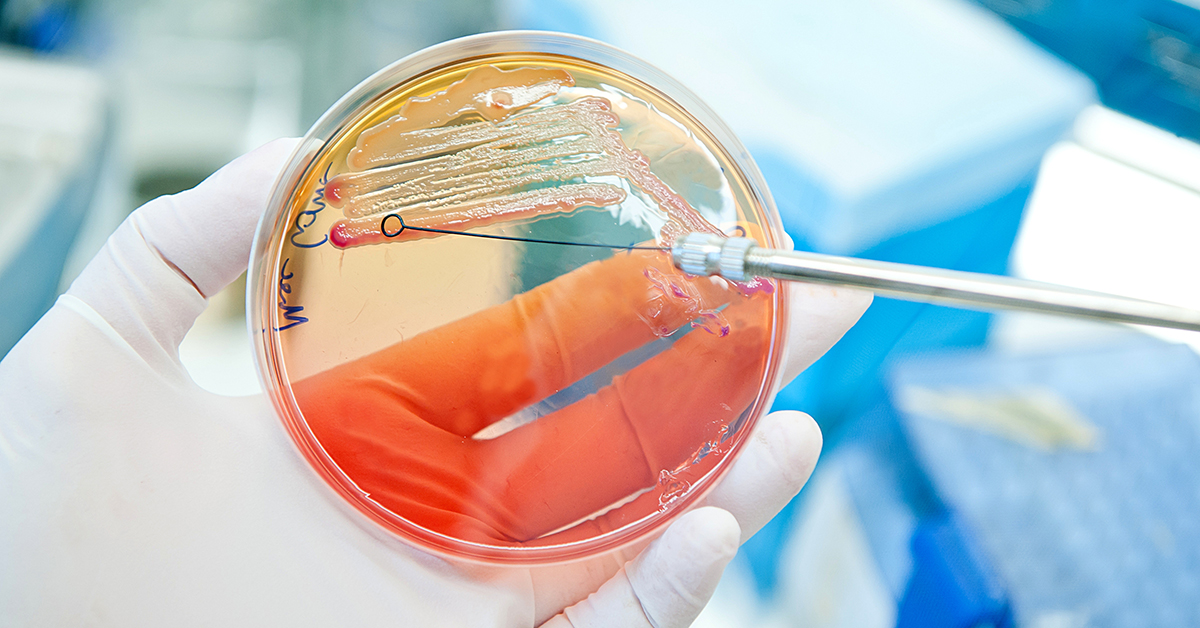

How to ensure robust challenge testing in process validations
21 May 2024 | Robert Limburn, Section Lead – Industrial Process Microbiology
Food business operators must validate their microbial kill steps. This applies whether you are applying a thermal process (anything from pasteurising and retorting through to extrusion, steam treatment, roasting and more) or a non-thermal process (e.g. high pressure processing, UV-C, infrared and irradiation), using an established or a new / emerging technology.
For any microbial kill step, you will need evidence that ensures your process is effective, repeatable and consistently produces safe products.
By helping you validate your process for the removal of microorganisms, we can help you ensure compliance to the relevant standards and best practices, ensure safe processes, and ultimately ensure safe products for your customers and consumers.
This blog explores some key considerations for conducting process validations, including challenge testing, and covers some specific examples of how we help ensure that worst case is validated for various products and processes.
Considerations for process validations
Temperature measurement is the most common method to validate a thermal process. However, there are a variety of different sensors and probes/thermocouples that can be used depending on your product type and heating environment. We can provide advice as to what the best temperature measurement solutions are for your process type or we can explore other methods of validation.
When the process does not allow for the use of temperature sensors, or there is a lack of available data, microbiological challenge tests can be a valuable option, demonstrating the log reduction achieved by processing equipment, including by non-thermal processing technologies. See the section below on challenge testing for more information.
For any validation, some key considerations include:
- What is the target organism and why? (consider heat resistance or other properties/resistance relevant to your product and process)
- What are the critical parameters of the process important for microbial inactivation?
- What is the variability of these parameters?
- How long does the product need to be held at these conditions?
- How consistent and representative are the conditions?
- What are the variabilities of the product characteristics and of the process?
- What are the worst-case conditions for the product and process?
All factors need to be considered so that you can understand the worst case variables and use these for validation
Validating the worst case scenario will ensure that the process conditions applied during normal production will always be covered by your validation (provided they remain within the established critical limits).
Using heat resistance studies (to assess the effect of product formulation on the efficacy of your process) and alginate particles (to directly measure the lethality delivered at the slowest heating point of a solid product or within a particulate) are just two examples of how we can help ensure that worst case is validated for thermal processes.
Heat resistance studies – in our containment level 3 lab
As well as determining how much heat has been applied to a food in a process, it is vital to know the susceptibility of the microorganisms in the product to that heat.
This is not straightforward, as microorganisms vary considerably in their heat resistance – not just between species, but also between strains. The physical characteristics (e.g. water activity, moisture, fat content, pH, total solids level) of the food in which the microorganisms are being heated, or have previously been subjected to, can also have a major effect.

We have a versatile, interchangeable containment level 2 (CL2) process hall in which we can test different pieces of equipment and different microbes (either the pathogen of concern or a surrogate organism). We also have a containment level 3 (CL3) laboratory where we can conduct heat resistance and other in vitro studies on Biosafety level 3 pathogens (such as Shiga toxin producing E. coli (STEC)), so that you can ensure that these extremely virulent pathogens are inactivated by your process.
Validating worst case – alginate particles
Food alginate particles are an extremely flexible and useful tool in microbiological process validations.
These particles, usually 1-3 mm in diameter, are comprised of inoculated, puréed food mixed with a small amount of sodium alginate as a gelling agent and a food grade dye or charcoal, allowing small, robust particles of uniform size to be formed.
The particles may be placed into the geometric centre of solid products and used to determine the lethality achieved at the slowest heating point of the product (e.g. within a joint of meat or a burger).
Alginate particle technology was originally conceived to test the lethality achieved within UHT heating systems in the dairy industry, and has been used more recently to validate the lethality achieved during continuous sterilisation of particulate products. Alginate particles can also be moulded to larger shapes and used to simulate particulates in food products, including products that contain multiple different food particulates.
Challenge testing
Challenge testing involves the inoculation of a product or an environment and the subsequent study of microbial inactivation, to demonstrate the impact of conditions that the product has been exposed to.
The design of challenge tests is as fundamental to the safety of your process as the choice of processing equipment.
Unfortunately, not all challenge tests are equal, and incorrect methods can lead to substantial under- or over-estimation of lethality.
International best practice guidance is increasingly available to support in the planning and execution of microbiological challenge tests and help standardise approaches across the industry, with highly respected international organisations including the National Advisory Committee for the Microbiological Safety of Foods (NACMCF) and the International Life Sciences Institute (ILSI) both having published detailed technical guidance. The International Standards Organisation (ISO) recently released part 2 of their “requirements and guidelines for conducting challenge tests of food and feed products”, which covers challenge tests to determine inactivation potential and inactivation kinetics (ISO 20976-2:2022).
Key considerations of challenge testing:
- Challenge testing environments and process settings should represent real-life conditions.
- Product characteristics should be considered and remain unaltered by inoculation (i.e. samples should be representative of a naturally contaminated product).
- Samples should reflect products to show a ‘real’ response to processing, as such –
- If the product is likely to be surface-contaminated, samples should be surface-inoculated;
- If the product is dry, inoculated samples should be dried to the same aw/moisture level;
- If a product is contaminated throughout, the samples should be inoculated homogenously;
- In a process, samples should be introduced to the whole process and retrieved as soon as possible after, with additional lethality avoided (e.g. samples sitting at high temperatures post-process).
- Surrogate microbes should closely match pathogens in terms of characteristics and response to processing.
- When no published information is available for a specific product to support the suitability of a surrogate in a processing scenario, it must be experimentally confirmed.
Challenge testing can be adapted and applied to practically any process and product. Roaster validations offer just one example, which we explore here.
Roaster validations
Roasters are typically used to process products such as cocoa nibs, nuts and seeds. Target microorganisms for such processes tend to be Salmonella.
For all validations by challenge testing, including roaster validations, we can compare inactivation rates (the heat resistance / process resistance) of pathogens in order to qualify an appropriately matched surrogate microorganism to be used in the challenge testing. In practice this means selecting a surrogate whose resistance is either the same or slightly greater than that of the target pathogen – ensuring that worst case is validated in the challenge test.
Using a surrogate (in place of e.g. Salmonella) means that roaster validations can be safely carried out in situ, at the client’s site, to ensure that the validation is fully representative, but poses no threat of contamination to the processing facility.
How our team can help
As experts in process validation and challenge testing, we understand the key considerations and can provide a thorough, bespoke proposal, undertaking challenge testing with a conscientious regard to all factors. We can validate both thermal and non-thermal processes that use both established and new / emerging technologies. Plus, we have the expertise and resources to conduct validations off-site or on-site / in situ.
We consider the nuances of processing food and the factors that may influence process validations and challenge testing, such as the variability involved in the vast array of different processes, regimes and products. With this in mind, we can advise on and undertake industry standard challenge testing (in accordance with the minimums recommended in current best practice) or enhanced testing for situations where there are higher degrees of variability.
When we undertake on-site validation, we also factor in the way challenge test samples are stored and transported, ensuring that samples stay in ‘stasis’ and the microbes within them do not grow or die off. We also include ‘transport controls’ which are inoculated samples taken to the site of a challenge test, stored in the same way as the challenge test samples (but not exposed to the process or regime) and used in the calculation of log reduction to ensure that transportation has not influenced the challenge test results and that the calculated log reduction reflects only the reduction in test organisms arising through exposure to the process under consideration.

About Rob Limburn
Rob has worked in Microbiology here within both Methods Research and Industrial Process Microbiology. He has been working in the food industry since 2004 and also has experience in allergens testing and authenticity testing.
Process validation and challenge testing – how can we help?
For more information or to secure support in validating your process, get in touch.
Find out more
If you’d like to learn more about our Microbiology services, click the button below.